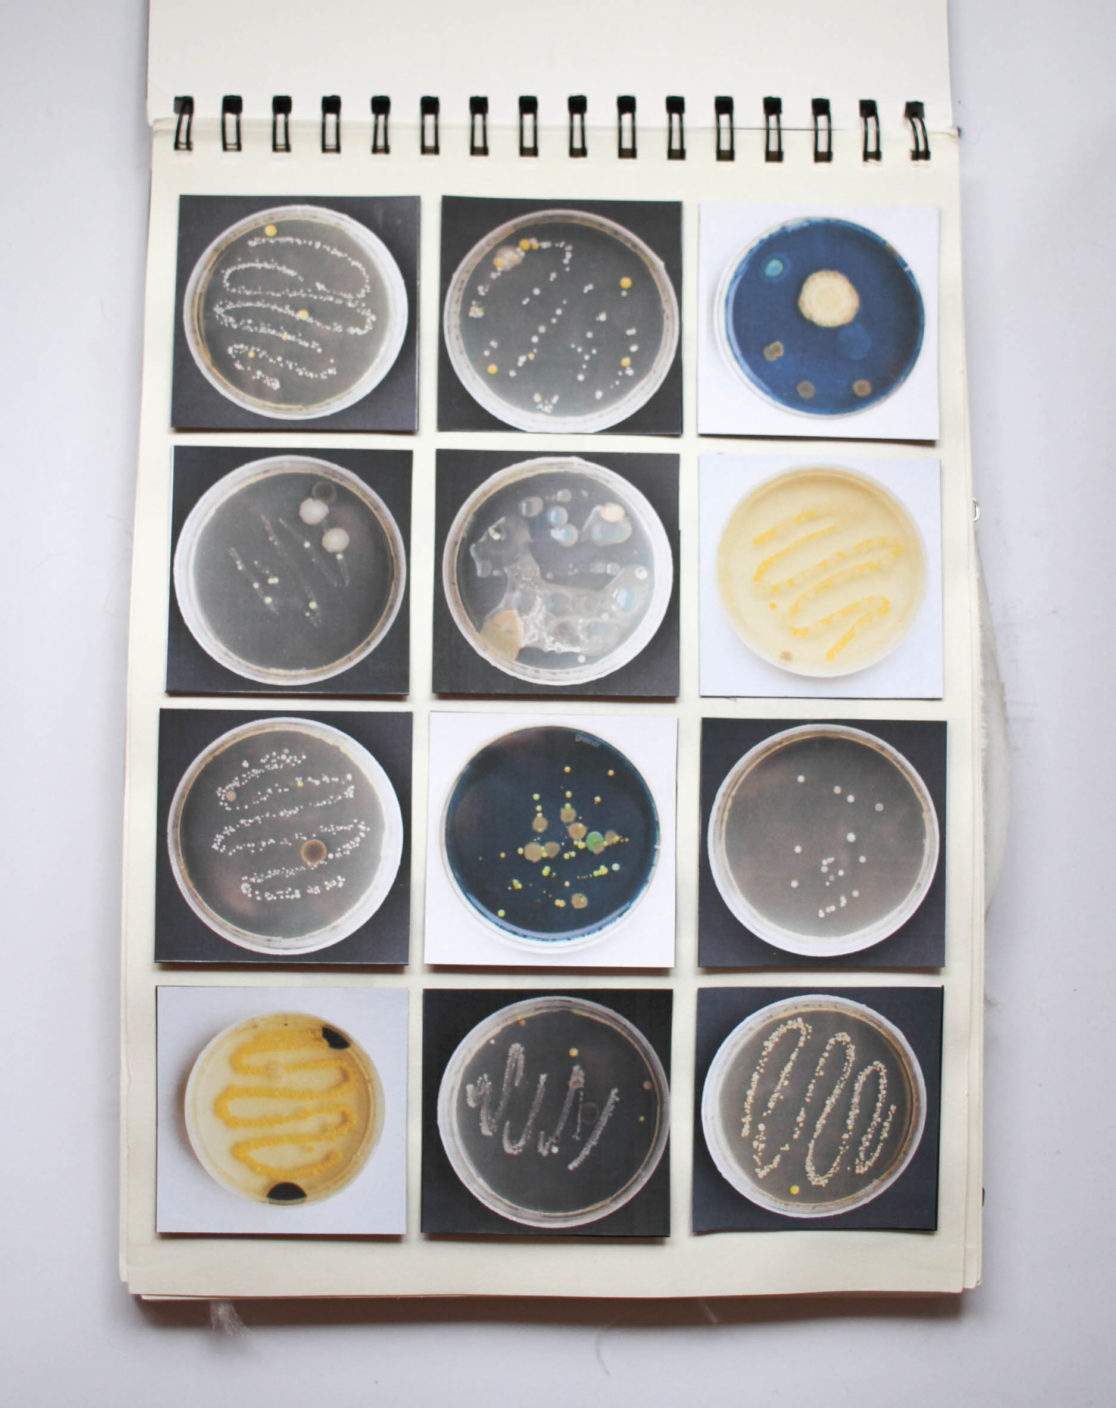

The Petri Dish Project
This project came to life when I was given the assignment of making a garment for Copenhagen’s “Culture Night”. The theme of the night was to be “The inner beauty of the body”.
I really like pictures of microscopic bacteria and bacteria in general, so I went out and got 30 petri dishes to grow my own bacteria in. They turned out better than I ever imagined, and so they became the primary inspiration for the rest of the project.
Materials
- 100% Satin Silk